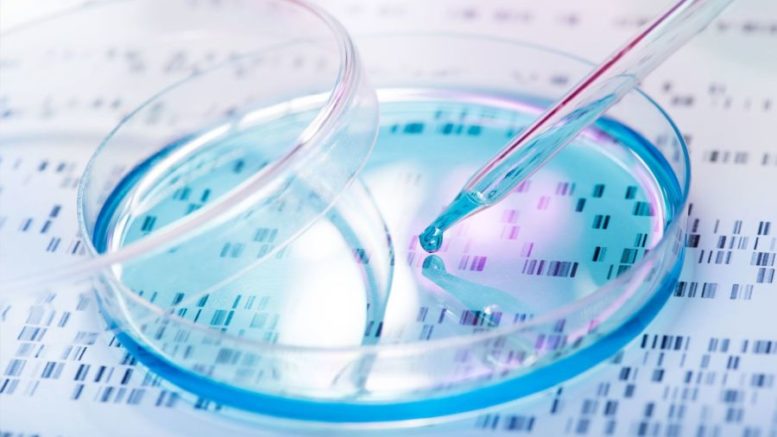

By GREGORY ZELLER //
That light at the end of the tunnel comes from the Northwell Health Cancer Institute, which provided hope – and bona fide bone marrowy health improvements – to a record number of patients last year.
As 2019 ticked down, staffers of the NHCI’s Don Monti Adult Stem Cell Transplant Program gathered inside North Shore University Hospital to recognize what Ruthee Lu-Bayer, chief of the Don Monti Bone Marrow Transplantation Unit, called “a monumental milestone”: the unit’s 100th stem cell transplant of the year.
While any cancer clinic worth its salt is going to embrace hope, joy can be a rare commodity – but the 100th stem cell transplant of 2019 triggered a full-on celebration at the Manhasset hospital, where stem cell transplants began in 1987 and are now performed in the 10-bed, inpatient Don Monti unit.
Complete with balloons, cake and a salute to “No. 100” herself – cancer-battling patient Teresa O’Halloran – the celebration assembled the unit’s myriad doctors, nurses and other professionals, with Bayer applauding “the combined efforts of every member of our staff who made this moment happen.”
“I always say that getting through their diagnosis is half the battle,” the board-certified medical oncologist noted. “When our patients arrive for transplant, I ask them to think of their transplant date as their second birthday, a time when they can begin to live their lives again.”

Century mark: Don Monti Bone Marrow Transplantation Unit chief Ruthee Lu-Bayer and “No. 100,” Teresa O’Halloran.
The gathering was also a celebration of the patients themselves, Bayer added, including O’Halloran, who’s fighting back against adult acute myeloid leukemia, a type of cancer in which the bone marrow produces abnormal white blood cells.
The 62-year-old East Islip resident, known affectionately as “No. 100” around the unit, received the tough diagnosis last August and was admitted to NSUH in December for a bone marrow transplant. Following several days of preparatory chemotherapy, she received her infusion as the calendar flipped to 2020 – and is now making “an unusually rapid recovery,” according to Northwell Health.
O’Halloran, who joined the celebration from the safety of her isolated recovery room, credits her faith and positive outlook – “I’ve always looked at the glass as half full,” she noted – and urged potential stem cell donors to check in with Be The Match, the national, nonprofit marrow-donor program.
“I wish everyone could understand how important it is to be tested as a possible match,” O’Halloran added. “It’s a simple cheek swab and you could wind up saving someone’s life.”